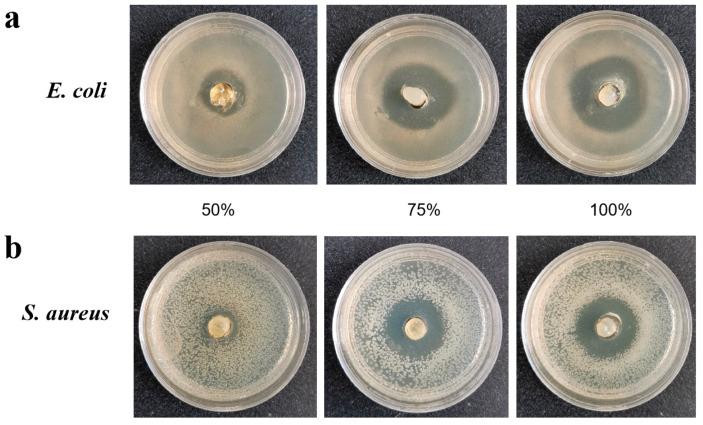

对虾抗菌肽3a转基因浮萍的抗菌潜力及水产养殖废水处理能力
The Antimicrobial Potential and Aquaculture Wastewater Treatment Ability of Penaeidins 3a Transgenic Duckweed.
作者信息
Yang Lin, Luo Ximeng, Sun Jinge, Ma Xu, Ren Qiuting, Wang Yaya, Wang Wenqiao, He Yuman, Li Qingqing, Han Bing, Yu Yiqi, Sun Jinsheng
机构信息
Tianjin Key Laboratory of Animal and Plant Resistance, College of Life Sciences, Tianjin Normal University, Tianjin 300387, China.
Tianjin Nankai Xiangyu School, Tianjin 300387, China.
出版信息
Plants (Basel). 2023 Apr 20;12(8):1715. doi: 10.3390/plants12081715.
With the development of aquaculture, wastewater treatment and diseases have been paid more and more attention. The question of how to improve the immunity of aquatic species, as well as treat aquaculture wastewater, has become an urgent problem. In this study, duckweed with a high protein content (37.4%) ( 5511) has been employed as a feedstock for aquatic wastewater treatment and the production of antimicrobial peptides. Penaeidins 3a (Pen3a), from , were expressed under the control of CaMV-35S promoter in duckweed. Bacteriostatic testing using the Pen3a duckweed extract showed its antibacterial activity against and . Transcriptome analysis of wild type (WT) duckweed and Pen3a duckweed showed different results, and the protein metabolic process was the most up-regulated by differential expression genes (DEGs). In Pen3a transgenic duckweed, the expression of sphingolipid metabolism and phagocytosis process-related genes have been significantly up-regulated. Quantitative proteomics suggested a remarkable difference in protein enrichment in the metabolic pathway. Pen3a duckweed decreased the bacterial number, and effectively inhibited the growth of Additionally, Pen3a duckweed displayed better growth in the lake. The study showed the nutritional and antibacterial value of duckweed as an animal feed ingredient.
随着水产养殖业的发展,废水处理和疾病问题越来越受到关注。如何提高水生物种的免疫力以及处理水产养殖废水已成为一个紧迫的问题。在本研究中,蛋白质含量高(37.4%)的浮萍(5511)已被用作处理水产养殖废水和生产抗菌肽的原料。凡纳滨对虾抗菌肽3a(Pen3a)在浮萍中由花椰菜花叶病毒35S启动子(CaMV-35S)控制表达。使用Pen3a浮萍提取物进行的抑菌测试表明其对[具体细菌1]和[具体细菌2]具有抗菌活性。野生型(WT)浮萍和Pen3a浮萍的转录组分析显示出不同的结果,并且蛋白质代谢过程是差异表达基因(DEG)上调最多的过程。在Pen3a转基因浮萍中,鞘脂代谢和吞噬作用过程相关基因的表达已显著上调。定量蛋白质组学表明代谢途径中蛋白质富集存在显著差异。Pen3a浮萍减少了细菌数量,并有效抑制了[具体细菌3]的生长。此外,Pen3a浮萍在湖泊中生长得更好。该研究表明浮萍作为动物饲料成分具有营养和抗菌价值。